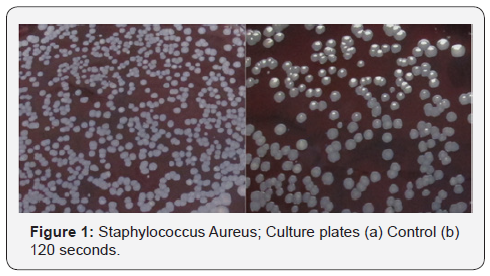
Click here to view Large Figure 1 Novel Techniques in Arthritis & Bone Research

Anti-Staphylococcal Effect of Ultrasonication
Kamineni Srinath1, Kamineni Ellora2, Kamineni Ashwin1 and Huang Chifu3
1Department of Orthopaedics and Sports Medicine, University of Kentucky, Lexington
2The Royal London and Barts Medical School, UK
3Center for Oral Health Research, University of Kentucky, Lexington
Submission: January 13, 2019; Published: January 25, 2019
*Corresponding author: Srinath Kamineni, Department of Orthopaedics and Sports Medicine, Elbow Shoulder Research Center, University of Kentucky, USA
How to cite this article: Kamineni S, Kamineni E, Kamineni A, Huang C. Anti-Staphylococcal Effect of Ultrasonication. Nov Tech Arthritis Bone Res. 2019; 3(3): 555615. DOI: 10.19080/NTAB.2018.03.555615
Abstract
Introduction: Diabetic foot ulcers are known to have a polymicrobial flora, including Staphylococcus, that is part of the reason for recalcitrant persistence. A recent application of ultrasonic debridement of diabetic foot ulcers has yielded promising clinical results. We investigated the effect of ultrasonic energy with respect to staphylococcal survival.
Methods: We investigated Staphylococcus aureus, a G-positive bacterium, from a commercial source. The bacteria were cultured and tested with sonication, using a Tenex Tx1 probe, for varying lengths of time (10, 30, 60, 120 seconds). The tested bacterial samples were plated, the number of colonies counted, and the anti-bacterial effect was calculated. A one-way analysis of variance was used for statistical analysis.
Results: A statistically significant time-dependent anti-staphylococcal effect was evident. The Staphylococcus Aureus had a 60% kill rate, when comparing the kill rate between the control and the 120 seconds of exposure. The Staphylococcus Aureus kill rate was statistically significant at all times, when comparing control to all of the time intervals tested (p=0.0001 – 0.004)
Conclusion: We demonstrate an anti-staphylococcal effect when these bacteria are exposed to ultrasonic energy, in a time dependent manner. The success of recalcitrant diabetic foot ulcers treated with ultrasonic debridement may be partially explained by this anti-staphylococcal effect of this treatment modality
Keywords: Ultrasonic; Debridement; Diabetic; Foot; Ulcer; Tenex
Introduction
Ultrasonic energy is utilized in some types of surgery, e.g. Cataract removal. Orthopaedic surgery utilizes ultrasonic energy for removing poly methyl methacrylate bone cement [1]. More recently focal tumor ablation [2,3] has been performed with this energy modality. Most recently recalcitrant diabetic foot ulcers have been successfully treated with ultrasonic debridement [4]. A possible hypothesis for this success is that there is a decrease in the poly-microbial burden that is known to exist in recalcitrant diabetic ulcers, as a consequence of the ultrasonic energy. This study investigates this hypothesis for treating diabetic ulcers; the anti-staphylococcal effect of a Tenex Tx1™ ultrasonic probe.
Materials and Methods
Bacterial Cultivation
Oral microbial species Staphylococcus aureus (ATCC 23235) was purchased from the American Type Culture Collection (Manassas, VA) [5,6]. TSBYE media was purchased from Oxoid Ltd. (Cambridge, UK). This strain of bacteria was cultured under the growth conditions of 37°C in Plas-Labs anaerobic chamber with 85% N2, 10% H2, and 5% CO2 (Lansing, MI).
Antibacterial Assay
Five ml of the overnight culture were placed in a test tube and tested, in triplicate. Sonication testing, with a TX1 ultrasonic probe (Tenex™, Lake Forest, CA), was performed with the active end of the probe submerged into the bacterial broth, but not touching the bottom of the test-tube. A thermometer placed in the bacterial broth, during testing, ensured the fluid temperature did not increase beyond 37.5°. Each test-tube of broth was sonicated for various time intervals (10, 30, 60, 120 seconds), in triplicate. After the treatment, 3 μl of the culture solution was diluted 105 times and plated to blood agar plates (Remel®). The plates were incubated aerobically at 37°C for 48 hours. The plates were then incubated for 48 hours at 37°C in an aerobic chamber. Then, the colony forming units (CFU) were counted for each plate [5,6].
Statistical Analysis
Data analysis was performed using a one-way ANOVA with multiple comparisons. Turkey’s post hoc adjustment was utilized to compare multiple groups, using SPSS v15 (IBM; Armonk, New York, USA). A p value of less than 0.05 was set for statistical significance. Results are shown as mean ± standard error.
Results
A statistically significant time dependent sonication effect was exhibited (Table 1). The Staph Aureus tested was not completed denatured at any of the times chosen for sonication exposure. The greatest anti-bacterial effect (the greatest reduction of colony forming units) was observed at 120, 90, and 60 seconds, while less effect was observed at 5, 10 and 15 seconds. Sonication was effective in reducing the CFU counts (Table 2). When comparing the kill rate between the control and 120 seconds of sonication the Staph Aureus had a 60% kill rate (Figure 1). When comparing control to all of the time intervals tested, the Staph Aureus was statistically significant at all times.
Discussion
Many studies have shown that ultrasonic energy can disrupt cell walls and diminish bacterial growth. Bacterial inactivation using ultrasound treatment was first reported in 1920s and the investigation of the mechanism of microbial inactivation began in 1960s [1-2]. Acoustic cavitation is thought to be the mechanism by which the mechanical effects and sonochemical reactions such as the generation of highly reactive radicals and molecular products such as H2O2. Although the inactivation of bacteria by high power ultrasound is well known, the effectiveness of lower ultrasound energies to inactivate bacteria is not yet well understood. Some reports showed that gram-negative bacteria were more sensitive to ultrasonic inactivation that gram-positive bacteria, while others reported no significant relationship between the gram-status of bacteria and ultrasonic inactivation.
This study demonstrates that a clinically available Tenex ultrasonic probe has an antibacterial effect against the commonly pathogenic gram-positive Staphylococcal Aureus species. Complete kill rates were not achieved, and there is a variation in the effect based on the time of active sonication, with greater sonication times leading to greater kill rates. This data may help to explain the ability for ultrasonic debridement to result in dramatic healing responses of long standing recalcitrant diabetic ulcers due to the physical diminution of the bacterial load within the lesion [2-4]. The study demonstrated that sonication technology could be used to kill bacteria; therefore, a potential anti-bacterial medical application. Limitations of the study included a single bacterial species, and a small number of trials. Further studies are needed to understand this technology with respect to a wider spectrum of clinically relevant bacterial species.
In conclusion, the Tenex Tx1 probe is effective at decreasing the number of bacterial colonies forming units in a time and species dependent manner. While it was unable to eliminate all Staphylococcal Aureus CFUs, it was effective at decreasing them by 60%, with sonication between 120 seconds. More extensive studies are needed in the future, but these current results are promising for the efficacy of procedures with bacterial burdens, notably diabetic foot ulcers, when debrided with the Tx1 ultrasonic probe.
References
- Shengpu Gao, Gillian D Lewis, Muthupandian Ashok kumar, Yacine Hemar (2014) Inactivation of microorganisms by low-frequency high-power ultrasound: 1. Effect of growth phase and capsule properties of the bacteria. Ultrasonics Sonochemistry 21(1): 446-453.
- Guoping Huang, Suwan Chen, Chunhua Dai, Ling Sun, Wenli Sun, et al. (2017) Effects of ultrasound on microbial growth and enzyme activity. Ultrasonics Sonochemistry 37: 144-149.
- NK Chammas, R L R Hill, M E Edmonds (2016) Increased Mortality in Diabetic Foot Ulcer Patients: The Significance of Ulcer Type. Journal of Diabetes Research.
- Anamika Bajpai, Sumati Nadkarni, Michael Neidrauer, Michael S Weingarten, Peter A Lewin, et al. (2018) Effects of Non-thermal, Non-cavitational Ultrasound Exposure on Human Diabetic Ulcer Healing and Inflammatory Gene Expression in a Pilot Study. Ultrasound in Medicine & Biology 44(9): 2043-2049.
- Huang CB, Ebersole JL (2010) A novel bioactivity of omega-3 polyunsaturated fatty acids and their ester derivatives. Molecular Oral Microbiology 25(1): 75-80.
- Huang CB, George B, Ebersole JL (2010) Antimicrobial activity of n-6, n-7 and n-9 fatty acids and their esters for oral microorganisms. Archives of Oral Biology 55(8): 555-560.






























